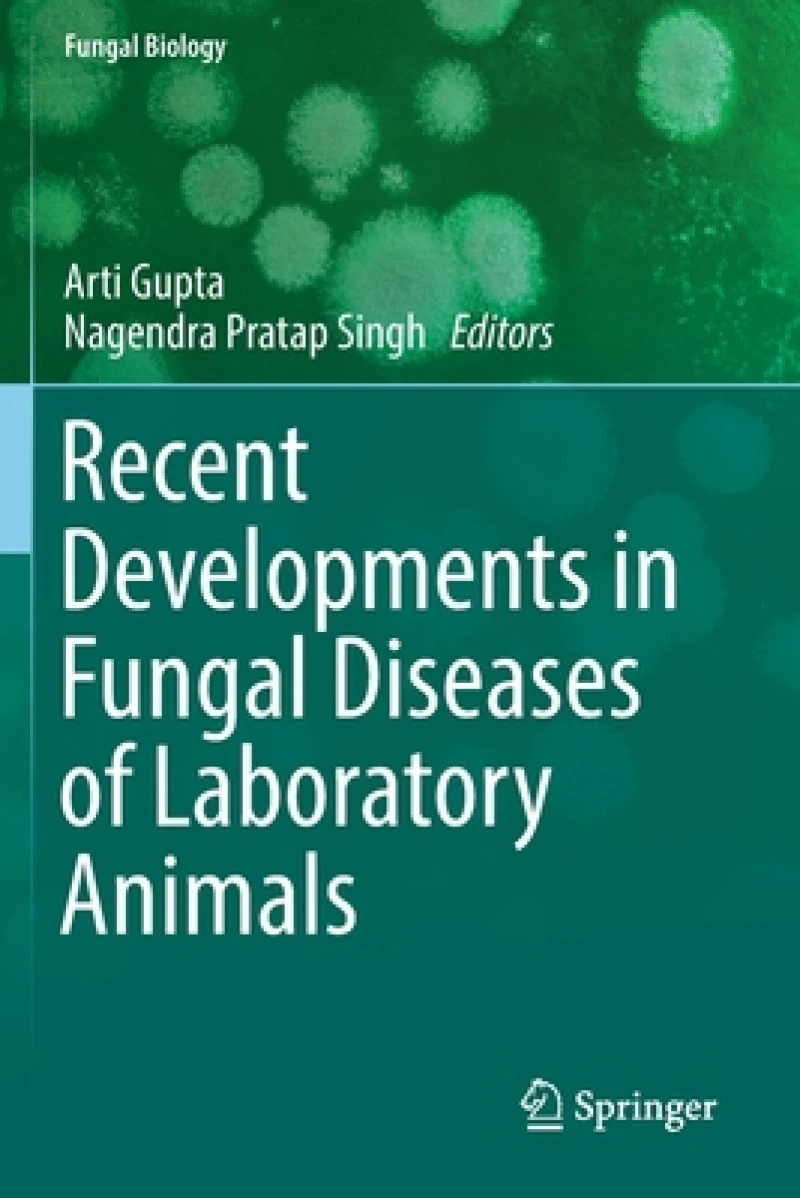
Recent Developments in Fungal Diseases of Laboratory Animals

Category
Veterinary medicine laboratory animals
Discover the best books in this category. Find your next great read.
40 Books
Showing 40
of 40 books
Showing 40 of 40 books
Veterinary medicine laboratory animals Books in Kenya
Looking for Veterinary medicine laboratory animals books? Werezi offers a wide range of titles in this category for all ages and interests. Browse our collection of bestsellers and hidden gems.